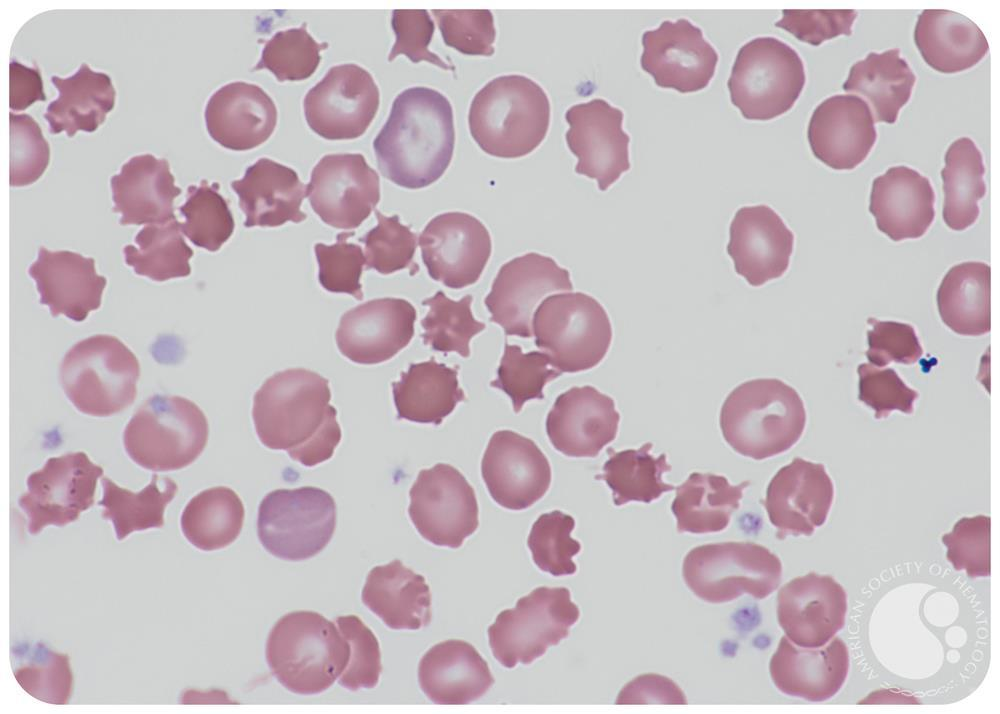
<p>contracted dense RBC with irreg membrane projections that vary in length and width</p>

1/76
Name | Mastery | Learn | Test | Matching | Spaced | Call with Kai |
|---|
No analytics yet
Send a link to your students to track their progress
list the common causes of obstruction in SI
hernia, intestinal adhesion, intussecption and volvulus
account for 80%
bowel obstruction distal to obstruction has a paucity of ____
gas
twisting of a loop of bowel about its mesenteric point of attachment
volvulus
volvulus results in what type of compromise
luminal and vascular
so youll have obstruction as well as infarction
x ray finding of coffee bean sign
volvulus
elderly have voluvlus in _______
YA have volvulus in _______
old = sigmoid
young =cecum
segment of intestine constricted by wave of peristalsis telescopes into immediately distal segment
intussectption
trapped and pulls mesentery along with it in subsequent peristalsis
classic triad of symptoms for intussception
colicky abodominal pain, biliuous vomiting, currant jelly stools
CT/US finding: target sign
adults: tumor
children: idiopathic, reactive lymphoid hyperplasia, meckel diverticulum, small bowel hematoma
causes of intussecption
abnormal protrusion of intraabdominal tissue through fascial defect in the abdominal wall
hernia
most hernias occur in the
groin
most frequent cause of intestinal obstruction worldwide
hernia
definitive treatment of hernia
surgery
surg procedures, infection or other causes of peritoneal inflammation such as endometriosis may result in
adhesions
fibrous bridges that can create closed loops throuhg which other viscera can slide and become trapped → obstrcution and strangulation
adhesions
mostly acquired but can be congenital in rare cases
adhesions
congential anomaly where bowel fails to canalize during weeks 3-7 of embryologic development.
results in obstruction adn ends in a blind loop
duodenal atresis

double bubble sign
duodenal atresia
polyhydramnios, bilious vomiting within first 24 hours of life
dudodenal atresia (compare with pyloric stenosis)
how is amniotic fluid produced
direct ransfer from maternal circulation
excretion of fetal urine by the kidneysk
kidney defects in utero result in
oligohydramnios
swalloing defects or absorption defects in utero leads to
polyhydramnios
outpuching of the bowel wall forming a true dicerticulum located in distal small bowel
meckel diverticulum
true diverticulum includes what layers
mucosa submucosa muscularis serosa
rule of 2s
in meckel diverticulum (diverTWOculum)
2% population
2% symptomatic
<2 years old
2:1 male to female
within 2 feet proximal to ileocecal valve
=< 2 inches long
2 types of mucosal lining (native ileal or heterotpic (gastric or pancreatic))
how are most cases of meckel diverticulum discovered
incidentally during surgery
acute inflammation of meckel diverticulum
meckel diverticulitis
same risk/complications of appendicitis
meckel diverticulitis
GI emergency in newbowns
inflammation and injury to intestinal mucosa due to gas producing bacteria that invade and release gas into bowel wall and portal venous system
NEC
neonatal necrotizing enterocolitis
where are most cases of NEC
very low birth weight infants born at less than 32 weeks gestation
immature intestinal tract and immunity
mucosal or full thickness necrosis
bowel perforation → DIC, shock, death
abdominal distension, bilious vomiting, bloody diarrhea
NEC
treatment of NEC
IV fluid, TPN, antibiotics, surgery
causes of ischemia/infarction in SI
arterial thrombosis
arterial emboli
venous thrombosis
generalized hypoperfusion
mucosal infarction most often occurs with
hypotension
mucosa is farthest from the blood supply
most due to emboli
sudden onset periumbilical pain out of proportion to findins
metabolic acidosis
acute mesenteric ischemia
most often due to athersclerosis
postprandial epigastric pain
avoid eating bc hurts → lose weight
chronic mesenteric ischemia
occlusion of the SMA often occurs with his
transmural infarction
loss of normal intestinal peristalsis, often due to surgery
adynamic ileus
abdominal distention, N/V, constipation, abdominal pain, lack of flatus
adynamic ileus
opitaes and anticholinergics are medication assoc causes of this
adynamic ileus
most receover with watchful wait and supportive care
other tc: iv fluid, electrolytes, avoid drugs that cause it, +- GI tube
adynamic ileus treatment
muation in gene encoding lactase (disaccharidase)
autosomal recessive
congenital lactase deficiency
symptoms aboate when milk exposure is temrinated
vili appear normal
congenital lactase deficiency
down regulation of lactase gene expression, common in native american african american and chinese population with increasing age
acquired lactase deficiency
can develop after infections and may resolve over time
abdominal fullness, flatulence, diarrhea
normal vili or injured from previous infection
acquired lactase deficiency
no source of ____________ in humans other than bacterial metabolism of carbohydrates
hydrogen gas
(post lactose hydrogen breath test)
lactose tolerance test
give them lactose, check and see if blood glucose goes up or not and also if there are symptoms
celiac disease is a type what hypersensitivity to gluten
type IV
most of the disease manifestation of celiac is related to
gliadin, alcohol soluble portion of gluten
how does gliadin results in tissue damage
is is deamidated by transglutaminase
demidated gliadin reacts with antigen presenting cells leading to stim of cd4+ lymphocytes that release cytokines that lead to tissue damage
increase in intraeptihelial lymphocutes marked atrophy r total loss of mili in more proximal small bowel (esp duodenum and prox jejunum), hyperplasia of crypts
celiac disease pathology
malabsorption as a result, may → microcytic anemia (iron def)
celiac
almost all celiac haplotype
HLA-DQ1 or HLA-DQ8
adults: chronic diarrhea, fatigue, may be asymptomatic
kids: irritable, abdominal distension, chronic diarrhea, failure to thrive, weight loss
celiac symptoms
associations and increased risk assoc with celiac
dermatitis herpetiformis
increased risk of t cell lymphoma and small bowel carcinoma
antibodies celiac disease
anti DGP, anti TTG anti EMA iga antibodies
iga def patietns → igg antibodies too
idiopathic celiacl like disease almost exclusively in people lving in or visting tropics
tropical sprue
I’d just die for biel
DIe: Duodenum Iron
Just For: Jejunum Folate
BIel: Ileum B12
rare systemic disease caused by trophermyma whipplei (gram pos rod bacteria)
whipple disease
any organ but most intestine mesenteric lymph nodes cns cardiac valves and joints
whipple disease
small bowel lamina propria with numerous macrophages filled with PAS postiive granules which are lysosomes stuffed with partially digested microorganism
macrophages compress lacteals and prevent chylomicrons from entering
fat malabsorption steatorrhea weight loss
whipple
rare autosomal recessive disease
loss of function mutation in MTP gene encoder
deficiency of apolopoprotein b-48 and apob100
acanthocytes seen on peripheral blood smear
abetalipoproteinemia
contracted dense RBC with irreg membrane projections that vary in length and width
acanthosis
seen in abetalipoproteinemia
low grade malignant neuroendocrine neoplasm
most in gi tract
carcinoid tumor
carcinoid tumors stain postivie for
synaptophysin
chromogranin
all gi sies: mucosa may be in tact or ulcerated and in the intestines the tumors may invade deeply to involve the mesentery
carcinoid tumor
yellow or tan in color and firm bc intense desmoplastic reaction →kinking of the bowel
carcinoid tumor
islands, trabeculae, strands, flansd, sheets of unifrom cells with scant pink granular cytoplasm and round to oval stippled nucleus
carcinoid
what do carcinoid tumors often secrete
serotonin
goes into portal venous system and metabolized by liver monoamine oxidase
can detect metabolite 5-HIAA in urine but will not get carcinoid syndrome
constellation of symptoms mediated by various humoral factors
flushing, bronchospasm, diarrhea, right sided cardiac valve fibrosis due to excess serotonin in pts with liver mets
alcohol adn stress can trigger
carcinoid syndrome
Be FDR
bronchospasm
flushing
diarrhea
right sided heart disease in carcinoid syndrome
most common tumor of appendic is a
carcinoid tumor
dilation of lumen of appendix by mucinous secretion usually in an appendix with dysplastic epithelium
mucocele
binign neoplasm, most common cause of mucocele
mucinous cystadenoma
malignant neoplasm
invasion through appendiceal wall → intraperitoneal seeding adn spread
resulting peritoneal implants may be mistaken for mucinous ovarian tumors
abdomen fills with semisolid mucin
mucinous cystadenocarcinoma
pseudomyxoma pertionei
abdomen fills with semisolid mucin in advance cases of mucinous cystadenocarcinoma
go make the appendicitis cards